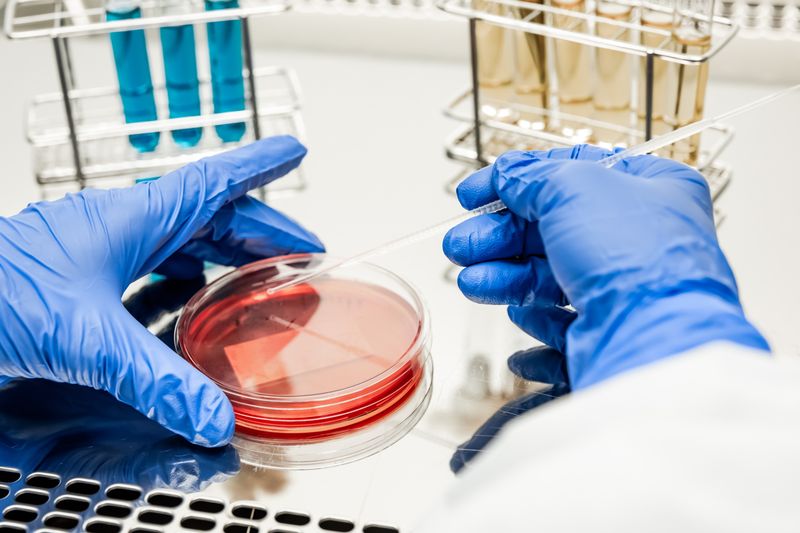
Грибок ногтей на ногах: Симптомы заболевания

Грибок ногтей на ногах: чем лечить, как вылечить быстро, эффективное лечение
Оглавление
ToggleГрибок ногтей на ногах: чем лечить болезнь?

Проблема грибкового поражения ногтевых пластин ног знакомы многим. По данным медицинской статистики, этот недуг беспокоит около 20 % населения планеты. Только на территории России страдают от грибка более 15 млн. человек. Поэтому проблема, чем лечить грибок ногтей на ногах, сегодня крайне актуальна. Эту болезнь в медицинской среде также называют онихомикозом. Недуг более распространен среди представителей сильного пола. Это связано с тем, что они чаще носят закрытую обувь. А это, в свою очередь, мешает поступлению к ногам воздуха, что способствует появлению благоприятной среды для быстрого размножения патогенных микроорганизмов.

Информация
проверена экспертом

Информацию из данного раздела нельзя использовать для самодиагностики и самолечения. В случае боли или иного обострения заболевания диагностические исследования должен назначать только лечащий врач. Для постановки диагноза и правильного назначения лечения следует обратиться к профильному специалисту.
Записаться на прием
Симптомы заболевания
Существует около 50 различных видов грибков, способных поразить организм человека. Поэтому, для того чтобы определить, чем лечить грибок ногтей на ногах, нужно узнать точный тип инфекции. Симптомы недуга также варьируются в зависимости от того, какой возбудитель его спровоцировал.
При заражении нормотрофическим грибком у больного:
- происходит изменение цвета ногтя;
- на нем появляются пятна и полосы;
- наблюдается онихолизис.
При атрофическом типе заболевания пациент отмечает, что у него медленно разрушается ноготь. Повреждения возникают в наружном конце и двигаются в направлении ногтевого валика. В начале на недуг указывает только изменение цвета пластины. Она становится:
В дальнейшем происходит полная потеря ногтя. При гипертрофическом грибке наблюдается утолщение пластины. Возникает это из-за усиленного роста чешуек кожи. Вследствие, ноготь может утолщаться до двух миллиметров, и сильно деформироваться. Указывают на появление этого недуга следующие симптомы:
- изменение формы ногтя (разрушаются боковые части);
- потеря блеска пластины;
- пожелтение ногтя.
Срочно начинать лечение грибка ногтей на ногах нужно при появлении признаков латерального и дистального поражения. Эти два типа заболевания часто встречаются в комплексе. Указывать на этот недуг будет:
- возникновение на ногте поперечных борозд;
- изменение цвета пластины (от сине-зеленого до черного);
- шершавость пораженных участков.
Заболевание заканчивается полной потерей ногтя, а также воспалением ногтевых валиков. Вне зависимости от типа поражения есть симптомы, которые беспокоят каждого пациента с грибком:
- зуд в пораженной зоне;
- расслоение пластины;
- крошение и потеря ногтя.
Причины
Грибок возникает из-за поражения тканей микотическими бактериями. Почти в 90 % случаев заболевание вызывают дерматомицеты. В более редких случаях возбудителями становятся грибы рода Кандида, а также плесневые микроорганизмы. Проникнуть вглубь ногтя патогены могут:
- через дорсальную часть ногтя;
- из-под дистального края;
- через проксимальный валик.
В первом случае грибки проникают вглубь ногтя. Этот путь заражения характерен для дерматомицетов. Во втором случае поражение возникает непосредственно под пластиной. Это сильно усложняет лечение грибка ногтей на ногах, ведь воздействовать препаратами непосредственно на место заражения сложно из-за его труднодоступности. Через проксимальный валик инфекция проникает редко. Чтобы грибок попал в ноготь, нужны определенные условия. Повышают риск заражения:
- механические повреждения области ногтя;
- ношение узкой и неудобной обуви;
- постоянный контакт с водой;
- повышенное потоотделение;
- воздействие на стопы химическими веществами;
- несоблюдение правил личной гигиены.

Заразиться грибком можно от больного человека. Возбудители недуга прекрасно сохраняются во влажных и теплых помещениях, поэтому инфицирование чаще всего происходит в душевых, бассейнах, аквапарках, банях общественного пользования. Грибок может передаться также при совместном использовании таких предметов:
- полотенец;
- мочалок;
- тапок;
- ножниц;
- пемз.

Мы в социальных сетях
Каждый день наши врачи делятся рекомендациями и помогают понять своё тело и отсрочить старение без сложных терминов.




